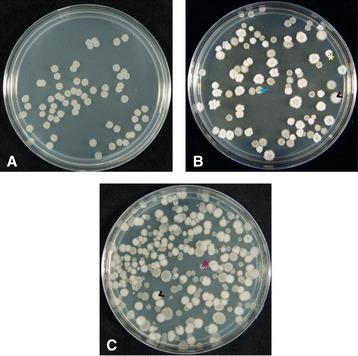
https://cdn.ncbi.nlm.nih.gov/pmc/blobs/d964/4258274/a19ca165e962/12866_2014_301_Fig1_HTML.jpg

SinR是枯草芽孢杆菌实验室进化菌株中用于微调生物膜形成的突变靶点。
SinR is a mutational target for fine-tuning biofilm formation in laboratory-evolved strains of Bacillus subtilis.
作者信息
Leiman Sara A, Arboleda Laura C, Spina Joseph S, McLoon Anna L
机构信息
Department of Molecular and Cellular Biology, Harvard University, Cambridge, MA, 02138, USA.
Biology Department, Colgate University, Hamilton, NY, 13346, USA.
出版信息
BMC Microbiol. 2014 Nov 30;14:301. doi: 10.1186/s12866-014-0301-8.
BACKGROUND
Bacteria often form multicellular, organized communities known as biofilms, which protect cells from a variety of environmental stresses. During biofilm formation, bacteria secrete a species-specific matrix; in Bacillus subtilis biofilms, the matrix consists of protein polymers and exopolysaccharide. Many domesticated strains of B. subtilis have a reduced ability to form biofilms, and we conducted a two-month evolution experiment to test whether laboratory culturing provides selective pressure against biofilm formation in B. subtilis.
RESULTS
Bacteria grown in two-month-long batch culture rapidly diversified their biofilm-forming characteristics, exhibiting highly diverse colony morphologies on LB plates in the initial ten days of culture. Generally, this diversity decreased over time; however, multiple types of colony morphology remained in our final two-month-old populations, both under shaking and static conditions. Notably, while our final populations featured cells that produce less biofilm matrix than did the ancestor, cells overproducing biofilm matrix were present as well. We took a candidate-gene approach to identify mutations in the strains that overproduced matrix and found point mutations in the biofilm-regulatory gene sinR. Introducing these mutations into the ancestral strain phenocopied or partially phenocopied the evolved biofilm phenotypes.
CONCLUSIONS
Our data suggest that standard laboratory culturing conditions do not rapidly select against biofilm formation. Although biofilm matrix production is often reduced in domesticated bacterial strains, we found that matrix production may still have a fitness benefit in the laboratory. We suggest that adaptive specialization of biofilm-forming species can occur through mutations that modulate biofilm formation as in B. subtilis.
背景
细菌常常形成多细胞的有组织群落,即生物膜,生物膜可保护细胞免受多种环境压力的影响。在生物膜形成过程中,细菌会分泌物种特异性基质;在枯草芽孢杆菌生物膜中,该基质由蛋白质聚合物和胞外多糖组成。许多驯化的枯草芽孢杆菌菌株形成生物膜的能力有所下降,我们进行了为期两个月的进化实验,以测试实验室培养是否会对枯草芽孢杆菌形成生物膜产生选择压力。
结果
在为期两个月的分批培养中生长的细菌,其生物膜形成特征迅速多样化,在培养的最初十天里,在LB平板上呈现出高度多样的菌落形态。一般来说,这种多样性会随着时间的推移而降低;然而,在我们最终的两个月龄群体中,无论是在振荡还是静态条件下,仍存在多种类型的菌落形态。值得注意的是,虽然我们最终的群体中产生生物膜基质比祖先菌株少的细胞,但也存在生物膜基质过量产生的细胞。我们采用候选基因方法来鉴定生物膜基质过量产生菌株中的突变,并在生物膜调节基因sinR中发现了点突变。将这些突变引入祖先菌株会模拟或部分模拟进化后的生物膜表型。
结论
我们的数据表明,标准的实验室培养条件不会迅速选择淘汰生物膜的形成。虽然驯化细菌菌株中生物膜基质的产生通常会减少,但我们发现基质产生在实验室中可能仍具有适应性优势。我们认为,生物膜形成物种的适应性特化可能通过调节生物膜形成的突变发生,就像在枯草芽孢杆菌中那样。